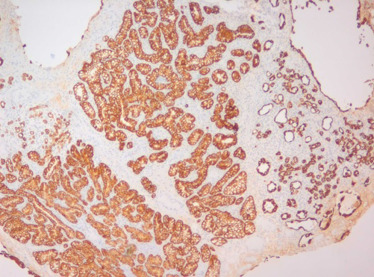
Estudo imunohistoquímico – expressão de citoqueratina 7; (100x).

Resumo
Introdução
O adenoma nefrogénico da bexiga (ANB) é uma variante rara e benigna dos tumores uroteliais. A literatura existente é escassa relativamente à sua etiologia, clínica e terapêutica. Este trabalho apresenta o primeiro caso descrito de um doente com infeção por vírus da imunodeficiência humana tipo 1 (VIH‐1) a quem foi diagnosticado um ANB.
Caso clínico
Doente do sexo feminino, 49 anos, seropositiva para VIH‐1. Seguida em consulta por quadro clínico consistente em polaquiúria, urgência miccional, sensação de esvaziamento vesical incompleto e episódios de hematúria intermitentes. Por apresentar uma lesão vesical suspeita foi submetida a uma RTU‐V. O exame anatomopatológico foi consistente com ANB. A doente encontra‐se em regime de follow‐up tendo completado um ano sem sinais de recidiva lesional.
Discussão
O ANB é uma lesão metaplásica do urotélio. A sua etiologia não está completamente esclarecida, encontrando‐se associada a processos inflamatórios crónicos ou a um estado de imunossupressão. O seu diagnóstico é histopatológico, caracterizando‐se pela presença de estruturas tubuloglandulares semelhantes aos túbulos renais. Este trabalho assume particular relevância pelo facto de ser o primeiro caso descrito de ANB numa doente imunodeprimida por infeção com VIH‐1.
Abstract
Introduction
Nephrogenic adenoma of the urinary bladder (NAB) is a rare and benign urothelial tumor. The existing literature is scarce regarding its etiology, clinical symptoms and therapeutic options. This paper presents the first reported case of a patient with HIV‐1 infection to whom an NAB was diagnosed.
Case Report
We report a case of a female patient of 49 years old, seropositive for HIV‐1, with pollakiuria, mictional urgency, feeling of incomplete bladder emptying and intermittent macroscopic hematuria. The patient was submitted to TURB of a suspected intravesical lesion. Histopathological examination of the resected material was consistent with an NAB. The patient is in follow‐up, having completed one year with no sign of lesion recurrence.
Discussion
NAB is a metaplastic lesion of the urothelial tissue. Its etiology is not fully understood. NAB is associated with chronic inflammatory processes or to a state of immunosuppression. Its diagnosis is histological, characterized by the presence of tubular structures similar to renal tubules. This work is particularly relevant because it is the first described case of NAB in a patient immunodepressed by HIV‐1 infection.
Palavras‐chave
Adenoma nefrogénico ; Bexiga ; Urotélio ; Vírus da imunodeficiência humana ‐ tipo 1 ; Imunodepressão
Keywords
Nephrogenic adenoma ; Urinary bladder ; Urothelium ; Human immunodeficiency virus‐1 ; Immunodepression
Introdução
O primeiro caso de adenoma nefrogénico da bexiga foi descrito em 1949 por Davis, que o classificou como um hamartoma vesical1 , sendo o termo «adenoma nefrogénico» criado por Friedman e Kuhlenbeck, em 1950, devido à sua estrutura histológica tubuloglandular, semelhante a túbulos renais2 .
O adenoma nefrogénico da bexiga é uma entidade rara e benigna, que ocorre mais frequentemente nos homens adultos. A sua etiologia é desconhecida, encontrando‐se associada a processos inflamatórios crónicos como infeções, trauma vesical, cirurgias urológicas, litíase, imunoterapia intravesical com o bacilo Calmette‐Guérin (BCG) e a processos indutores de imunossupressão1 ; 3 ; 4 .
A literatura existente é escassa relativamente aos aspetos clínicos, modalidades terapêuticas e regimes de follow‐up desta patologia. Apesar de existirem algumas séries publicadas, a sua origem histológica e linha de diferenciação continuam por esclarecer.
Este trabalho pretende apresentar o primeiro caso descrito de um doente imunodeprimido por infeção com vírus da imunodeficiência humana tipo 1 (VIH‐1), a quem foi diagnosticado um adenoma nefrogénico da bexiga, realizando para o efeito uma revisão da literatura existente sobre esta patologia.
Caso clínico
Os autores descrevem o caso de uma doente de 49 anos de idade, caucasiana e doméstica, que foi referenciada a consulta externa de Urologia em junho de 2013, na sequência de um quadro clínico consistente em polaquiúria, urgência miccional, sensação de esvaziamento vesical incompleto e episódios recorrentes de hematúria com 6 meses de evolução.
A doente apresentava como antecedentes patológicos conhecidos seropositividade para VIH‐1, desde 2005, e tuberculose pulmonar em 2011, realizando como medicação habitual: atazanavir 300 mg, ritonavir 100 mg, tenofovir + emtricitabina (245 mg + 200 mg) e bromazepam 6 mg. Referia, também, hábitos tabágicos ocasionais.
O estudo da doente e a realização de exames complementares de diagnóstico revelaram uma citologia urinária negativa para células neoplásicas e urocultura negativa. Realizou uma uretrocistoscopia que foi considerada suspeita pela presença de uma lesão infracentimétrica localizada no fundo vesical, plana, eritematosa e de aspeto bolhoso. A doente foi, posteriormente, submetida a ressecção endoscópica da lesão em causa. A cirurgia decorreu sem complicações, tendo realizado instilação intravesical única de mitomicina‐C no pós‐operatório (40 mg diluídos em 50 mL de soro fisiológico).
O estudo anatomopatológico revelou tratar‐se de uma lesão epitelial constituída por estruturas tubuloglandulares revestidas por células cuboides de citoplasma claro, com infiltrado inflamatório linfoplasmocitário e edema do estroma associados (fig. 1 ). Não se identificaram nucléolos, mitoses, necrose nem desmoplasia. Algumas estruturas continham mucinas neutras (PAS +) e mucinas ácidas (Alcian Blue +) intraluminais (fig. 2 ). O estudo imunohistoquímico mostrou expressão de citoqueratina 7 (fig. 3 ), P504s (alfa‐methylacyl coenzime A racemase [AMARC]) (fig. 4 ) e índice proliferativo (Ki67/mib1) baixo, inferior a 2%. Para o diagnóstico diferencial foram também estudados outros anticorpos: citoqueratina 20, p53, p63, CA125 e CEA, que foram negativos. Pelas características morfológicas e imunohistoquímicas, foi realizado o diagnóstico de adenoma nefrogénico da bexiga.
|
|
|
Figura 1. Estruturas tubuloglandulares revestidas por células cuboides de citoplasma claro (setas), com infiltrado inflamatório linfoplasmocitário e edema do estroma associados (Hematoxina/Eosina; 200 x). |
|
|
|
Figura 2. Estruturas tubuloglandulares com mucinas neutras (PAS +) e mucinas ácidas (Alcian Blue +) intraluminais (400 x). |
|
|
|
Figura 3. Estudo imunohistoquímico – expressão de citoqueratina 7; (100 x). |
|
|
|
Figura 4. Estudo imunohistoquímico – expressão de P504s (alfa‐methylacyl coenzime‐A racemase [AMARC]); (200 x). |
O período pós‐operatório decorreu sem intercorrências, não tendo realizado qualquer terapêutica adjuvante. A doente encontra‐se em regine de follow‐up , com realização de cistoscopias e citologias urinárias periódicas (aos 3 meses após cirurgia e, posteriormente, em intervalos de 6 meses até aos 5 anos), após adaptação das guidelines da European Association of Urology (EAU) para o follow‐up de tumores vesicais de risco intermédio 5 , tendo já completado um ano de pós‐operatório sem sinais de recidiva tumoral.
Discussão
O adenoma nefrogénico, também denominado metaplasia nefrogénica ou metaplasia adenomatoide, é uma lesão metaplásica do urotélio, que ocorre em resposta a um processo inflamatório6 , e é considerada uma lesão benigna e rara7 .
Esta lesão ocorre no trato geniturinário, mais frequentemente na bexiga (80%), mas também na uretra (15%), ureter (5%) e, raramente, na pélvis renal (< 1%), divertículos vesicais ou em condutos ileais3 ; 8 ; 9 ; 10 . Apresenta uma prevalência superior no sexo masculino, com uma relação de 3 : 19 , e ocorre maioritariamente nos indivíduos de idade adulta, havendo, contudo, casos publicados em indivíduos de idade pediátrica11 .
A etiologia do adenoma nefrogénico não está completamente esclarecida, encontrando‐se a maioria dos casos associada a um processo inflamatório crónico, secundário a fatores como irritação vesical por corpos estranhos, traumatismo geniturinário, antecedentes de cirurgia vesical, cateterização recorrente ou de longa duração, anomalias anatómicas e irradiação pélvica prévia12 ; 13 . A instilação intravesical de BCG8 , a tuberculose geniturinária e a ingestão crónica de fenacetina e ibuprofeno são outros fatores descritos com possíveis etiologias do adenoma nefrogénico2 ; 13 ; 14 . Uma maior prevalência de casos em doentes submetidos a transplantação renal sugere que a imunossupressão possa ser também um fator contribuinte15 .
O caso clínico descrito corresponde a uma doente sem antecedentes geniturinários conhecidos, sendo o único fator de risco documentado a imunodeficiência secundária a infeção por VIH‐1.
Existem 2 teorias explicativas da histogénese do adenoma nefrogénico da bexiga: alguns autores caracterizam‐na como sendo uma lesão metaplásica do urotélio vesical; contudo, mais recentemente, alguns autores têm considerado o adenoma nefrogénico da bexiga como uma lesão verdadeiramente «nefrogénica» secundária à proliferação de células tubulares renais esfoliadas e implantadas ao longo do trato urinário, num processo semelhante ao mecanismo da endometriose14 .
A apresentação clínica do adenoma nefrogénico é inespecífica, cursando frequentemente com sintomas irritativos como polaquiúria, disúria e urgência ou, mais raramente, hematúria micro ou macroscópica3 ; 8 . A aparência macroscópica é variável, sendo geralmente uma lesão hipervascularizada4 , com aspeto papilar (55%), séssil (35%) ou polipoide (10%). A maioria apresenta‐se como uma lesão única e pequena, medindo menos de 1 cm de diâmetro; contudo, cerca de 10% apresentam um diâmetro superior a 4 cm2 ; 8 ; 16 .
Devido ao seu aspeto e clínica inespecíficos, o seu diagnóstico é histológico e caracteriza‐se pela presença de estruturas tubuloglandulares revestidas por uma camada de epitélio cuboide, semelhantes aos túbulos renais, ausência de atipia e de atividade mitótica, coloração PAS extracelular positiva, membranas proeminentes e presença de infiltrado inflamatório no interstício celular4 ; 6 ; 17 ; 18 .
Do diagnóstico diferencial, na bexiga, fazem parte carcinoma uroteliais, nomeadamente a variante microquística, o adenocarcinoma e o carcinoma urotelial com pequenos túbulos, bem como adenocarcinomas metastáticos14 .
O adenoma nefrogénico é considerado uma lesão de comportamento benigno2 ; 4 ; 12 ; contudo, pode ocorrer associado a neoplasias uroteliais, adenocarcinomas ou carcinoma de células escamosas da bexiga19 ; 20 ; 21 . Em séries com um longo follow‐up , o adenoma nefrogénico apresenta uma elevada taxa de recorrência (38‐75%) 4 ; 22 . Assim, apesar do adenoma nefrogénico ser considerado uma lesão benigna, existem registos de casos com transformação maligna, o que sugere tratar‐se de uma lesão pré‐maligna, particularmente nos indivíduos imunodeprimidos23 . Pensa‐se que a variante maligna do adenoma nefrogénico corresponda ao raro adenocarcinoma mesonéfrico24 , ocorrendo também associado a carcinomas de células de transição25 .
Apesar de não existirem normas de orientação clínica específicas para o adenoma nefrogénico da bexiga, a ressecção transuretral é considerada a melhor opção diagnóstica e terapêutica. A elevada taxa de recorrência e potencial degeneração neoplásica são a favor de um regime de follow‐up apertado e longo, através da realização de citologias urinárias, ecografias vesicais e cistoscopias 12 ; 14 .
Este trabalho descreve, assim, uma patologia rara mas presente na prática clínica, assumindo particular relevância pelo facto de ser o primeiro caso descrito de adenoma nefrogénico numa doente imunodeprimida por infeção VIH‐1.
Responsabilidades éticas
Proteção de pessoas e animais
Os autores declaram que os procedimentos seguidos estavam de acordo com os regulamentos estabelecidos pelos responsáveis da Comissão de Investigação Clínica e Ética e de acordo com os da Associação Médica Mundial e da Declaração de Helsinki.
Confidencialidade dos dados
Os autores declaram ter seguido os protocolos do seu centro de trabalho acerca da publicação dos dados de pacientes.
Direito à privacidade e consentimento escrito
Os autores declaram ter recebido consentimento escrito dos pacientes e/ou sujeitos mencionados no artigo. O autor para correspondência deve estar na posse deste documento.
Conflito de interesses
O autor declara não haver conflito de interesses.
Referências
- 1 T.A. Davis; Hamartoma of the urinary bladder; Northwest Med., 48 (1949), pp. 182–185
- 2 N.B. Friedman, H. Kuhlenbeck; Adenomatoid tumor of the bladder reproducing renal structures (nephrogenic adenoma); J Urol., 64 (1950), pp. 657–670
- 3 C. Martínez-Sanchíz, J. Martínez-Ruiz, P.J. Anguita-Fernandez, J.M. Giménez-Bachs, M. Atiénzar-Tobarra, J.A. Rodríguez, et al.; Vesical nephrogenic adenoma: An unusual presentation of a bladder tumour; Can Urol Assoc J., 5 (5) (2011), pp. E79–E80
- 4 R. Boscolo-Berto, C. Lamon, M. Gardi, R. Vezzaro, M. Gardiman; Recurrent nephrogenic adenoma in bladder diverticulum: Case report and literature review; Can Urol Assoc J., 6 (2) (2012), pp. E34–E37
- 5 M. Babjuk, M. Burger, R. Zigeuner, S.F. Shariat, B.W. van Rhijn, E. Compérat, et al.; EAU guidelines on non‐muscle‐invasive urothelial carcinoma of the bladder: Update 2013; Eur Urol., 64 (4) (2013), pp. 639–653
- 6 E. Dres Rochman, O. Damia, R. Sicher, V. Villalba; Adenoma nefrogénico ‐ Consideraciones clínicas; Rev Arg de Urol, 71 (3) (2006), pp. 186–187
- 7 L. Llanes Gonzáles, E. Martin Osés, I. Fernández Gonzáles, J.M. Rodríguez Barbero, J.L. Ruiz Rubio, C. Llorente Abarca, et al.; Adenoma nefrogénico vesical: descripción de un caso; Arch Esp Urol., 51 (1998), pp. 923–925
- 8 A.B. Porcaro, A. d‘Amico, V. Ficarra, M. Balzarro, R. Righetti, G. Martignoni, et al.; Nephrogenic adenoma of the urinary bladder: Our experience and review of the literature; Urol Int., 66 (2001), pp. 152–155
- 9 T.F. Ford, G.M. Watson, K.M. Cameron; Adenomatous metaplasia (nephro‐genic adenoma) of urothelium. An analysis of 70 cases; Br J Urol., 57 (4) (1985), pp. 427–433
- 10 R.H. Young, R.E. Scully; Nephrogenic adenoma. A report of 15 cases, review of the literature, and comparison with clear cell adenocarcinoma of the urinary tract; Am J Surg Pathol., 10 (1986), pp. 268–275
- 11 A. Heidenreich, T.K. Zirbes, S. Wolter, U.H. Engelmann; Nephrogenic Adenoma: A rare bladder tumor in children; Eur Urol., 36 (4) (1999), pp. 348–353
- 12 C.S. Chen, C.L. Cheng; Nephrogenic adenoma of the urinary bladder: Clinical experience and review of the literature; J Chin Med Assoc., 69 (4) (2006), pp. 166–168
- 13 C.A. Dhaliwal, P.W. Fineron; The progression of nephrogenic metaplasia of the urinary bladder to clear cell adenocarcinoma: A case report; Curr Urol., 6 (2) (2012), pp. 106–108
- 14 B. Kuzaka, P. Pudełko, A. Powała, B. Górnicka, P. Radziszewski; Nephrogenic adenoma of the urinary bladder: A report of three cases and a review of the literature; Ann Transplant., 19 (1) (2014), pp. 153–156
- 15 S. Banyai-Falger, U. Maier, M. Susani; High incidence of nephrogenic adenoma of the bladder after renal transplantation; Transplantation., 65 (1998), pp. 511–514
- 16 T.L. McIntire, M.S. Soloway, W.M. Murphy; Nephrogenic adenoma; Urology., 29 (1987), pp. 237–241
- 17 M.L. Pierre-Louis, J. Kovi, A. Jackson, A. Ucci, V.W. Pinn-Wiggins; Nephrogenic adenoma: A light and electron microscopic and immunohistochemical study; J Natl Med Assoc., 77 (3) (1985), pp. 201–205
- 18 V. Grasa Lanau, R. Guarch Troyas, M. Montesino Semper; Nephrogenic adenoma: Study of 9 cases, including one of the urethra in a 14‐year‐old male; Arch Esp Urol., 51 (2) (1998), pp. 138–144
- 19 B.W. Berger, S.B. Bhagavan, W. Reiner, R. Engel, H. Lepor; Nephrogenic adenoma: Clinical features and therapeutic considerations; J Urol., 126 (6) (1981), pp. 824–826
- 20 D.M. Butterworth, N.Y. Haboubi, E.W. Lupton; Mixed mesonephric adenocarcinoma and transitional cell carcinoma of the bladder; Histopathology., 16 (6) (1990), pp. 601–604
- 21 D.P. Wood Jr., S.B. Streem, H.S. Levin; Nephrogenic adenoma in patients with transitional cell carcinoma of the bladder receiving intravesical thiotepa; J Urol., 139 (1) (1988), pp. 130–131
- 22 A.N. Husain, A.R. Armin, G.A. Schuster; Nephrogenic metaplasia of urinary tract in children: Report of three cases and review of the literature; Pediatr Pathol., 8 (3) (1988), pp. 293–300
- 23 R.E. Schultz, M.J. Bloch, J.E. Tomaszewski, J.S. Brooks, P.M. Hanno; Mesonephric adenocarcinoma of the bladder; J Urol., 132 (1984), pp. 263–265
- 24 A. Bannowsky, C. van der Horst, J.A. Sotelino, S. Sugimoto, B. Wefer, K.P. Juenemann; Mesonephroid adenocarcinoma of the bladder: A rare tumor in urology; J Urol., 170 (2003), pp. 2381–2382 6 Pt 1
- 25 V. Tse, M. Khadra, D. Eisinger, A. Mitterdorfer, J. Boulas, J. Rogers; Nephrogenic adenoma of the bladder in renal transplant and non‐renal transplant patients: A review of 22 cases; Urology., 50 (5) (1997), pp. 690–696
Document information
Published on 11/04/17
Licence: Other
Share this document
Keywords
claim authorship
Are you one of the authors of this document?